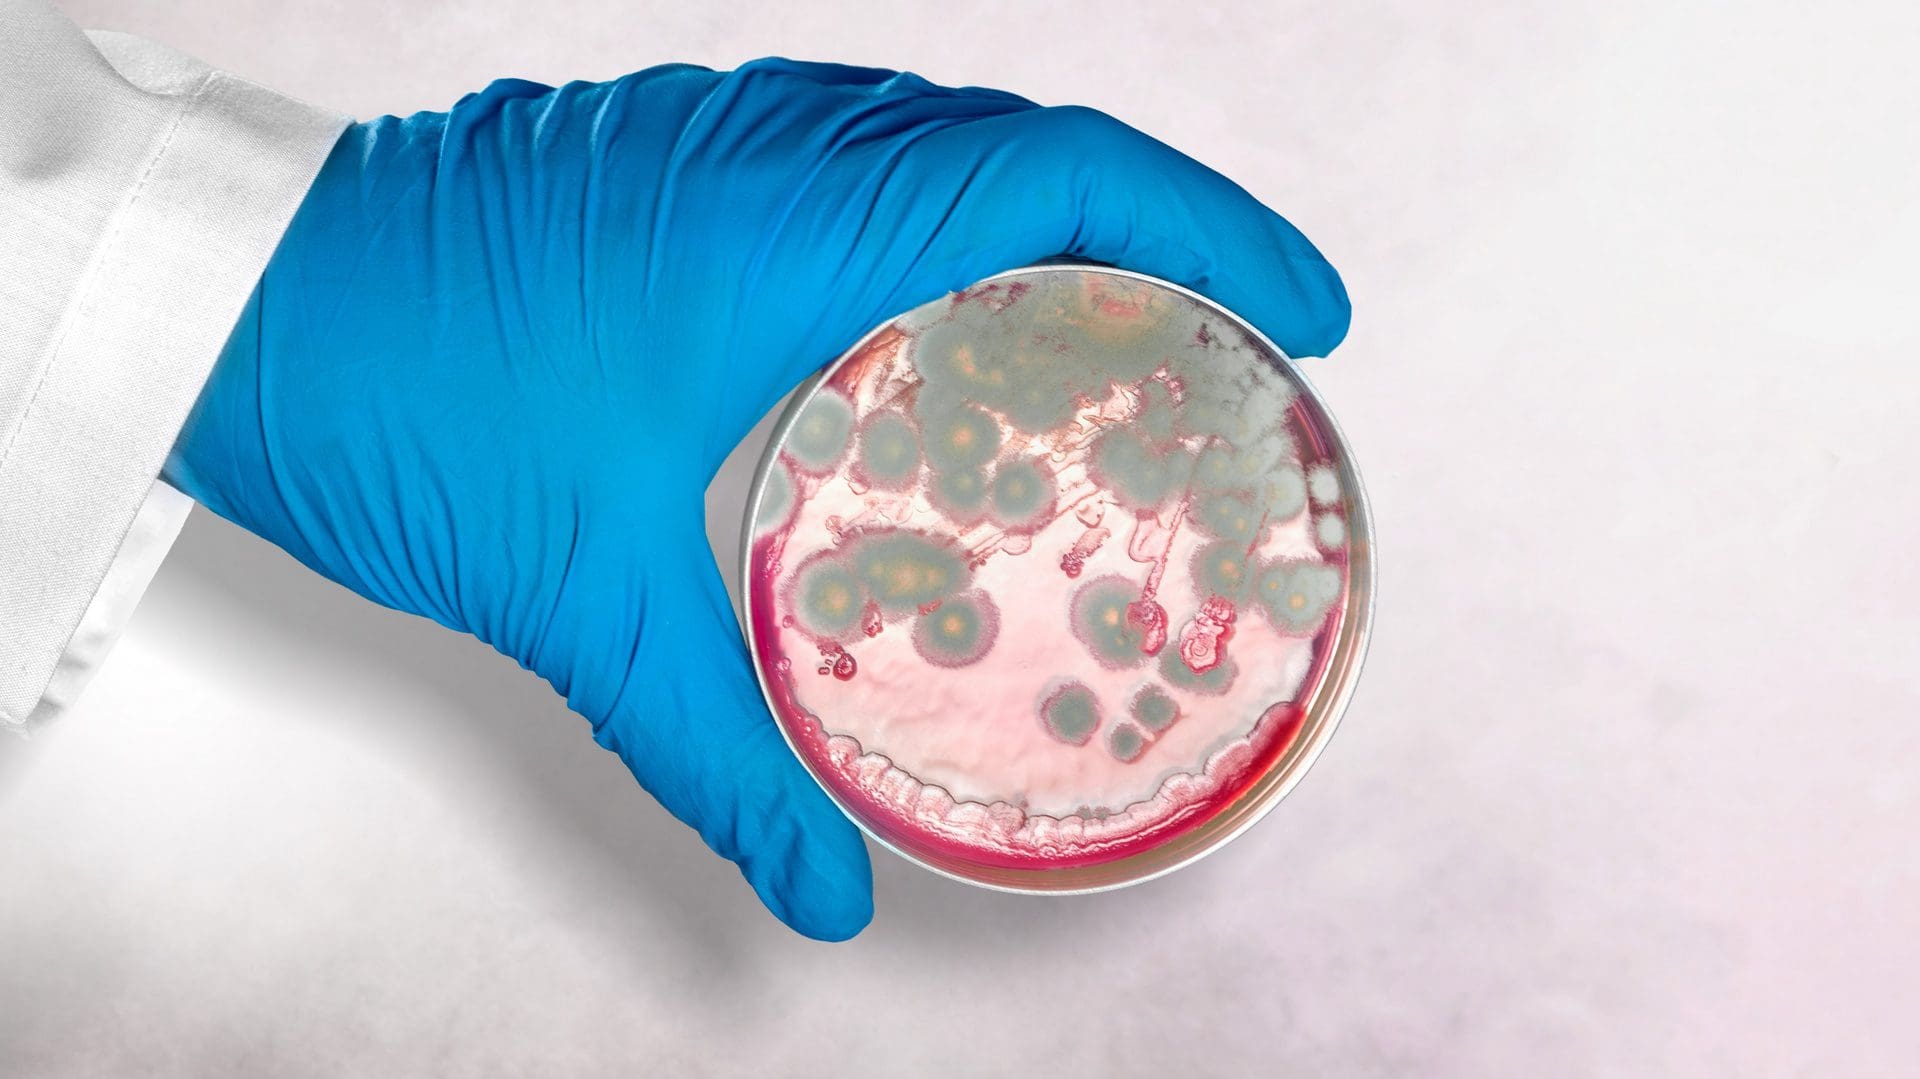
Schimmelcheck: Ist das roter Schimmel aus dem Bad, der Dusche, der Badezimmer-Wand? (© Billionphotos.com / stock.adobe.com)

Roten Schimmel im Bad erkennen, behandeln und zukünftig vermeiden
Leider sind Ausblühungen auf der Wand in der Küche oder im Bad vielen Hauseigentümern und Mietern durchaus bekannt. Besonders die grünen oder weißen Schimmelsporen finden sich häufiger in schlecht gelüfteten Wohnräumen oder auch im Keller. Wir wollen uns hier mit einer Besonderheit beschäftigen, nämlich dem roten Schimmel. Der tritt zwar seltener auf, ist aber nicht minder gefährlich für die Gesundheit der Bewohner.

Was sind die Ursachen für roten Schimmel im Bad?
Der Experte stellt für den Schimmelbefall meist nicht nur eine einzige Ursache fest. Viele Faktoren kommen in Frage, und es treten auch oft mehrere gleichzeitig auf. Zu nennen sind zunächst eine erhöhte Durchfeuchtung der Raumluft und ein Baukörper, der bereits Feuchtigkeit aufgenommen hat. Beides begünstigt das Anwachsen des Befalls auch bei rotem Schimmel.
Das Bad ist vielfach besonders betroffen, weil durch Aktivitäten, die der Reinlichkeit dienen, die Luftfeuchtigkeit hier besonders hoch ist. An der Wand oder den Fugen lagert sich die nasse Raumluft ab und hält die Umgebung auf einem hohen Feuchtigkeitslevel, was auch den roten Schimmel begünstigt. Siehe auch: Undichte Fliesenfugen Dusche und Wasserschaden unter Fliesen sowie Wasserschaden durch Duschabfluss.
Mit Messgeräten den Schaden analysieren
Der Schimmelexperte setzt zunächst entsprechende Messgeräte ein, um die Ursache zweifelsfrei festzustellen. Mit einem Hygrometer bestimmt er die Höhe der Luftfeuchtigkeit, und mit dem Feuchtigkeitsmesser erkennt er den Zustand von Wand und Fliesen. Mit diesen Methoden stellt sich schnell und zuverlässig heraus, wie man bei der Bekämpfung des roten Schimmels und der anschließenden Sanierung (siehe Schimmelsanierung: Schimmel entfernen) vorgehen sollte.
Bei einer relativ konzentrierten Feuchtigkeit in der Wand, die in die Umgebung ausstrahlt, lässt sich ein winziges Leck in einem Wasserrohr vermuten. Dies begünstigt den Schimmelbefall und seine weitere Ausbreitung. Die Feuchtigkeit dringt mit der Zeit im Inneren der Baukomponenten, in Betonsteinen oder im Putz weiter vor und breitet sich schließlich im gesamten Gemäuer aus. Dabei bleibt das Problem für die Bewohner lange unbemerkt und wird erst durch den Schimmelbefall offensichtlich. Siehe auch: Schimmelbefall feststellen.
Was tun gegen roten Schimmel im Bad?
Zunächst sollte der Hausbesitzer den Befall zeitnah entfernen, wie unten beschrieben, und siehe auch hier. Aber auch die Feststellung der Ursache sollte bald folgen. Kann der Fachmann keine besondere Undichtigkeit im Leitungssystem feststellen, liegt wahrscheinlich eine mangelhafte Belüftung vor, die zu dem Befall mit Schimmelsporen geführt hat. Also das Badezimmer immer ausreichend und besonders nach dem Duschen anhaltend lüften, damit kann man einem Befall mit Schimmel verlässlich vorbeugen.
Grundsätzlich hilft eine regelmäßig durchgeführte Stoßlüftung, also mehrmals am Tag für fünf bis zehn Minuten die Fenster öffnen. Das gilt für das Badezimmer auch an den Tagen, an denen es nicht oder wenig benutzt wird. Die kaum genutzten Räume sollte man dennoch durchgehend beheizen, damit die Bildung von Kondenswasser ausbleibt, das eine wesentliche Bedingung für das Entstehen von Schimmelpilz ausmacht (vgl. Schimmel an Fenstern).
Beim Kochen entsteht Wasserdampf, der sich in der gesamten Küche verteilt. Deshalb verwendet die clevere Hausfrau eine Dunstabzugshaube, die den Dampf ableitet. Oder sie öffnet während der Zubereitung der Nahrung das Fenster, denn Lüften wirkt ähnlich wie die technische Vorrichtung und verhindert eine Schimmelbildung ebenso zuverlässig.
Wie lässt sich Rotschimmel entfernen?
Wer selber gegen den Befall vorgehen will, verwendet am besten Ethylalkohol, und zwar mit einem Alkoholanteil von 80 Prozent (vgl. Schimmelflecken entfernen, Schimmelwand sanieren). Die Flüssigkeit wird im betroffenen Badezimmer einfach auf die befallenen Stellen, also auf Fuge oder Wand, mit einem Pinsel oder Lappen aufgetragen. Anschließend die Schimmelflächen gründlich abreiben. Niemals aber den Belag trocken abwischen, dadurch setzt man die Sporen nämlich nur unnötig frei und verteilt sie ungewollt in der Atemluft. Der Fachmann und damit auch der proaktive Hausbesitzer tragen eine Atemschutzmaske (FFP2) und verwenden die Schutzbrille sowie Gummihandschuhe. Die Alkoholdämpfe erfordern eine ausreichende Belüftung.

Was hilft gegen roten Schimmel?
Neben dem Ethylalkohol haben sich auch handelsübliche Schimmelentferner (in kleineren Fällen) vielfach bewährt. In Bad und Dusche trägt man sie den Herstellerangaben entsprechend auf, nicht ohne die genannten Schutzvorkehrungen zu treffen. Die Schutzbrille ist besonders wichtig, wenn sich der Schimmelpilz auf den Wänden ausgebreitet hat und der Sanierer über Kopf arbeiten muss. Meist werden die Schimmelsporen eingesprüht, und nach einer gewissen Wirkzeit wischt man mit einem feuchten Tuch die Sporen einfach ab.
Manche nutzen auch Essig zum Bekämpfen der Sporen, was aber umstritten ist. Sie geben Essigessenz auf einen Schwamm oder Lappen, so dass er gut getränkt ist, wischen den betroffenen Bereich ab und lassen den Reiniger eine Stunde wirken. Anschließend werden die Wände oder Fliesenfugen abgebürstet (Schutzbrille!) und es wird mit Wasser nachgespült. Allerdings hat Essig auch Kehrseiten, und kann dem Schimmel an bestimmten Stellen und Materialien zusätzlichen Nährboden geben. Das Mittel wird als „Hausmittel“ zwar von manchen Verbrauchern gern genutzt, gilt aber gemeinhin nicht als Empfehlung.
Übrigens können sich bei Silikonfugen die Sporen tief ins Material hineinfressen, dann sind alle beschriebenen Reiniger machtlos und es hilft nur noch eine Sanierung der Fuge.
Rote Ablagerungen in der Dusche: Ist das wirklich Rotschimmel?
Die roten Ablagerungen in der Dusche können zwar auch Roststellen in der Duschwanne sein. Grundsätzlich ist aber immer Vorsicht geboten, wenn die Fliesenfugen, Wände oder der Duschvorhang rötliche Verfärbungen aufweisen. Der Schimmel in der Dusche oder anderswo im Badezimmer erfordert also immer eine genaue Analyse, damit Gesundheitsprobleme für die Zukunft vermieden werden. Siehe auch: Siphon Dusche undicht.
Wie gefährlich ist roter Schimmel?
Der rote Schimmel tritt als Vertreter unterschiedlicher Pilzarten auf. Auf Obst und Gemüse wächst Fusarium. Neurospora crassa besiedelt hingegen gerne Mais und Weizen, also auch Backwaren. Auf feuchten Wänden oder Fugen findet sich aber der Aspergillus versicolor, dessen Färbung mit der Zeit variiert von einem anfänglichen Weiß oder Gelb bis zu Rot, Pink oder sogar Grün.
Fusarium und Aspergillus sind in der Lage, Allergien hervorzurufen. Bei Menschen, die unter einer Immunschwäche leiden, drohen Infektionen. Bei einigen Schimmelarten vermuten Mediziner eine Begünstigung von Krebserkrankungen. Dies alles sind gute Gründe, um den Schimmel in Bad und Dusche nicht auf die leichte Schulter zu nehmen und baldmöglichst für Abhilfe zu sorgen.

Nicht nur bei rotem Schimmel: Frag besser einen Anwalt
Viele trauen sich nicht zu, den roten Schimmel selber zu sanieren. Verständlich, denn immerhin drohen bei einigen Schimmelarten und einem unsachgemäßen Vorgehen ernsthafte gesundheitliche Gefahren (vgl. Mittel gegen Schimmel an der Wand). In unserem Experten-Netzwerk finden Sie Profis, die mit der Schimmelbekämpfung bestens vertraut sind und wissen, wie man zukünftige Beeinträchtigungen verhindert.
Bei einem Befall mit rotem Schimmel kann sich die Ursache auch auf dem Grundstück oder im Haus des Nachbarn befinden. Eine undichte Wasserleitung des städtischen Versorgers führt ebenfalls zu Feuchteschäden. Meist sind in all diesen Fällen Rechtsstreitigkeiten unvermeidlich, und Sie sollten sich mit einem Rechtsbeistand beraten.
Dann ist bald auch ein Gutachter gefragt, der die Schadensursache ermittelt und seine Erkenntnisse vor Gericht überzeugend darstellen kann. Wir vermitteln auf unserer Webseite die notwendigen Kontakte zu Bauexperten, Fachanwälten und Sachverständigen, die Sie mit all ihrem Fachwissen bei den Auseinandersetzungen unterstützen und Ihnen zu Ihrem Recht verhelfen. – Nehmen Sie jetzt hier für eine Erstberatung Kontakt zu uns auf!





